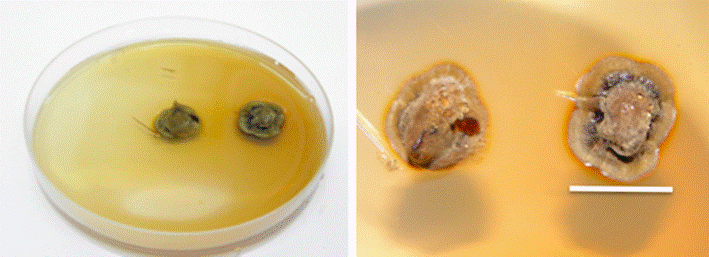

Serviços Personalizados
Journal
Artigo
Indicadores
-
 Citado por SciELO
Citado por SciELO -
 Acessos
Acessos
Links relacionados
-
 Similares em
SciELO
Similares em
SciELO
Compartilhar
Revista mexicana de ciencias forestales
versão impressa ISSN 2007-1132
Rev. mex. de cienc. forestales vol.9 no.50 México Nov./Dez. 2018
https://doi.org/10.29298/rmcf.v9i50.238
Articles
Boletus luridellus (Murr.) Murrill and Quercus fusiformis Small: pure culture, synthesis of mycorrhizas and sporocarp production in nursery
1Facultad de Ciencias Forestales, Universidad Autónoma de Nuevo León. México.
2Laboratorio de Micología, Instituto Tecnológico de Ciudad Victoria. México.
3Instituto de Ciencias Biomédicas. México.
4Escuela Nacional de Ciencias Biológicas, Instituto Politécnico Nacional. México.
4Instituto de Silvicultura e Industria de la Madera, Universidad Juárez del Estado de Durango. México.
5Departamento Forestal, Universidad Autónoma Agraria Antonio Narro. México.
This study documents the first register of Boletus luridellus (family Boletaceae) in the states of Nuevo León and Tamaulipas. Pure cultures were obtained in vitro; synthesis of mycorrhizae was achieved with Quercus fusiformis, and fruiting bodies were produced under greenhouse conditions for the first time. This species forms mycorrhizae with Quercus fusiformis, Q. polymorpha and Q. canbyi, in its natural environment. This species has a good potential for inoculation of oak seedlings in order to obtain better seedling growth under greenhouse conditions in northeastern Mexico, where oaks are currently planted in urban gardens, parks and new urban developments. This symbiosis is interesting because it occurs in a dry geographic zone where temperatures are high during the summer. Boletus luridellus is reported to be an edible species that grows well and produces sporocarps on a yearly basis (another experiment) in the gardens of the School of Forest Science in Linares, Nuevo León.
Key words: Boletaceae; Boletus luridellus (Murr.) Murrill; pure culture; sporocarps production; synthesis of mycorrhizae; Quercus fusiformis Small
Se presenta el primer registro de Boletus luridellus (Boletaceae, Boletineae) para los estados de Nuevo León y Tamaulipas, México. Se identificó la especie y se obtuvieron cultivos puros in vitro, se midió el crecimiento en dos medios de cultivo, se obtuvo la síntesis de micorrizas en plántulas de Quercus fusiformis y se regristra por primera vez la producción de esporomas de esta especie en condiciones de invernadero. En las entidades citadas, B. luridellus forma ectomicorrizas con Quercus fusiformis, Q. polymorpha y Q. canbyi, porque tiene potencial para producción de plántulas inoculadas de encino en vivero o invernadero, en el noreste de México, donde se utilizan frecuentemente para arborizar áreas urbanas, parques y nuevos fraccionamientos. Dicha simbiosis es de interés porque ocurre en una zona geográfica donde las temperaturas son altas durante el verano y el hongo puede inducir resistencia a sequía y mejorar crecimiento de las plantas. Se ha comprobado que Boletus luridellus crece bien en campo y produce esporomas cada año en los jardines del campus de la Facultad de Ciencias Forestales en Linares, Nuevo León, además se cita como comestible en la literatura especializada.
Palabras clave: Boletaceae; Boletus luridellus (Murr.) Murrill; cultivo puro; producción de frutos; síntesis de micorrizas; Quercus fusiformis Small
Introduction
The mushrooms of the family Boletaceae have ecological and economic importance; they are fleshy and form mycorrhizae with various plant species ―particularly with those of Ericaceae, Fagaceae, Pinaceae, Dipterocarpaceae, and Caryophyllaceae―, and a few of these mushroom species are saprobes (Arora, 1986, 2008; Tedersoo et al., 2010; Sitta and Davoli, 2012; Dentinger and Suz, 2014; Álvarez et al., 2017).
These macromycetes have been widely studied, using methods from the classical and molecular taxonomy in different regions of the world (Smith and Thiers, 1971; Corner, 1972; Both 1993; Bessette et al., 2000; Muñoz, 2005; Kuo, 2013).
The collection and trade of certain species such as Boletus edulis Bull., B. aereus Bull. and B. pinophilus Pilát & Demerek are important sources of income both, for the collectors and for the processing companies of several countries, including the United States of America, Canada, Mexico, Spain, Italy, Portugal and France (Villarreal et al., 1995; Águeda et al., 2006, Garza et al., 2009; Agreda et al., 2010; Garza et al., 2011).
Several diversity studies have been conducted in Mexico on Boletaceae taxa (García, 1999), and there are records of 212 species which belong to 27 genera ascribed to the Boletaceae, Gyroporaceae, Suillaceae, Paxillaceae, Gyrodontaceae and Boletinellaceae families. The diversity of species of this group across the country is greater if it is taken into account the new molecular studies, as well as the large variety of ecological, climate, soil type, vegetation and altitude conditions existing in the national territory (García and Garza, 2000). However, studies on the obtainment of cultures or on the inoculation of oak or pine seedlings with Boletaceae taxa are scarce.
The present study documents the first record of Boletus luridellus (Murr.) Murril in the states of Nuevo León and Tamaulipas, in association with Quercus fusiformis Small., Q. polymorpha Schltdl. et Cham. and Q. canbyi Trel. Furthermore, a pure in vitro culture was obtained, along with the first synthesis of its mycorrhiza with Quercus fusiformis and the production of sporomes under nursery conditions.
Materials and Methods
Sporocarp collection
Boletus luridellus species were collected from various localities of the states of Nuevo León and Tamaulipas and examined for the herbarium; their morphological and ecological data and their color in fresh state were recorded (Maerz and Paul, 1930). The microscopic analysis of the material was conducted using a Primo Star Carl Zeiss compound microscope with an ocular micrometer, KOH (5 %) and Melzer’s solution. The identification of the material was based on the studies by Singer (1986), García (1999), and Bessette et al. (2000; 2016).
In vitro culture
The strains were isolated in a laminar flux bell; small pieces of tissue of the context of young sporomes were removed using fine sterile tweezers and opened longitudinally with a sterile scalpel. They were placed on several lines on Melin-Nokrans solid culture medium with a pH of 6.5 in Petri dishes (Garza et al., 2014). The dishes were incubated at 25 oC in the darkness.
Having isolated the four strains in a pure culture, an experiment was conducted in order to measure the radial growth on a daily basis, during one month, in vitro in the Melin-Norkrans culture media and Malt Extract Agar. Ten replications were utilized for each strain and culture medium (a total of 80); pH was adjusted to 6.5, and growth was measured in orthogonal lines marked at the base of the Petri dishes.
A variance analysis (ANOVA) and a mean comparison test (p≤0.05) were made using the SPSS statistical software package, 2.0 version, in order to assess the significant differences in the relationship between the media and the strains.
Production of mycorrhizal inoculum
The four strains were used individually in the mycorrhization of oak seedlings; inoclulant was produced from each of these, in 500 mL wide-mouth jars, with vermiculite and peat moss (proportional volume 4:1), moisturized (to 70 %) with a modified Melin-Norkrans liquid culture medium (Garza et al., 2014). The jars with the substrate were sterilized at 120 oC during 40 minutes; they were then left to cool and were later individually inoculated with fresh mycelium obtained from the Petri dishes with Melin-Norkrans solid medium.
The jars were incubated during five weeks at 25 oC, in the dark, and shaken on a weekly basis in order to accelerate the colonization process of the substrate.
Germination of Quercus fusiformis seeds
The acorns were obtained from trees previously established in the gardens of the Facultad de Ciencia Forestales de la Universidad Autónoma de Nuevo León, UANL (School of Forest Science of the Autonomous University of Nuevo León). They were superficially sterilized with H2O2 at 30 % during 15 minutes; they were subsequently washed with sterile distilled water in three 15-minute cycles in order to eliminate the excess peroxide. The germination was carried out in Petri dishes, in water with 1.6 % agar, placed in the dark in a ShellabTM LI20 incubator at 25 oC during one week.
Inoculant substrate mix
The inoculant substrate in each strain consisted of a mixture of 50 % inoculant washed with sterile distilled water and 50 % sterile vermicompost soil. The sterile acorns which germinated during one week were placed upside down, half buried in the substrate in groups of 10 in each 250 mL styrofoam container cup, adding up to a total of 100 cups and 1000 acorns. 25 container cups (250 seedlings) were inoculated with each strain; the bottom of each cup was pierced at four points using a sterile scalpel in order to favor drainage. The cups were then placed in a nursery during six months (November to April) at an average temperature of 26 oC and relative humidity of 60 %.
Mycorrhization percentage
The percentage of mycorrhizae in the root system of the plants was determined through random sampling of 10 container cups, i.e. 100 seedlings per strain (adding up to a total of 400). The complete root systems were drawn from the cups and washed in the laboratory with distilled water in order to eliminate all residues of soil particles. The tips of the roots with mycorrhizae were counted using a Zeiss Stemi 2000C stereomicroscope. Their morphology was observed under a Primo Star Carl Zeiss microscope; fine cross-cuts were made in order to observe the Hartig network and measure the fungal mantle (Brundrett et al., 1996).
Results and Discussion
Taxonomic description
Boletus luridellus (Murr.) Murrill Mycologia 30:525. 1938.
Synonymy
Ceriomyces luridellus Murr. Mycologia 30: 523.1938.
Ceriomyces subsensibilis Murr. Mycologia 31: 111. 1939.
Boletus subsensibilis Murr., Mycologia 31: 112. 1939.
Convex pileus with a 36 to 105 mm diameter and a smooth, viscid to partly tomentous surface of an orange to reddish brown (6E8 - 7E8 K. & W.) or yellowish brown hue (5D7 - E7) (Maerz and Paul, 1930), and with slightly appendiculate margins.
Subattached hymenophore with 5 - 12 mm long tubes, of an olive yellow color, stained blue when exposed; angular, with pores of a 0.3 - 0.7 mm diameter, of a 3C8 yellow color, stained blue when exposed.
75 - 110 × 13 - 29 mm subcylindrical stipe with an acute base and a strongly reticulated surface, except in the lower third, where it is smooth or slightly pruinose, of a 4B6 K. & B. yellow color (Maerz and Paul, 1930) in its upper part, and reddish purple, reddish brown or copper red at its base; the reticulation is concolored with the surface of the stipe; it stains blue rapidly when touched.
Context 1.2-2.0 cm thick, yellow, stains blue rapidly when exposed, with a slightly acidic or sweet fruity odor and taste, according to the ripeness of the specimens.
The KOH on the pileus reacts producing a reddish brown color, with an orange hue in the context and surface of the stipe, and with orange brown pores. The NH4OH on the pileus produces a dark brown color, with a somewhat ochre-like color, dark olive brown pores and orange to olive-colored stipe.
Spores sized (11.2-) 12 - 15 (-19) × 4 - 5.6 (-6.4) μm, ellipsoid to fusoid, smooth, some with a subacute apex or inversely attached; some with a thick wall of up to 1 - 1.2 mµ, of an olive brown color in KOH, and orange brown in Melzer’s solution. Olive brown spore print.
Basidia sized 20 - 32 × 8 - 12.8 μm, hyaline in KOH, and with a granular content in Melzer’s solution. Pleurocystidia sized 26 - 48 × 8 - 10 μm, fusoid-ventricose, with medium-sized necks and a subacute apex, hyaline or yellowish in KOH and in Melzer’s solution.
Cheilocystidia sized 32 - 40 × 7.2 - 9 μm, fusoid to somewhat ventricose, with a subacute apex, of a pale yellowish hue in KOH and in Melzer’s solution.
Bilateral trama of the tubes, with a middle layer of somewhat gelatinized hyphae and a lateral layer of tubular hyphae, both with hyaline cells in KOH and in Melzer’s solution, and with a 3.5 - 6 μm diameter.
Epicutis formed by a trichoderm of interwoven hyphae, with terminal elements of cylindrical, claviform or cystidioid hyphae, most of them with a rounded apex, sized 36 - 77 × 6.4 - 11.2 μm, with a few short, intermingled subglobous to claviform elements, sized 26 - 32 × 10.4 - 13 μm, hyaline or of a pale yellow color in KOH and orange in Melzer’s solution.
Stipe surface formed by a layer of cystidioid subglobous cells, some of them of a sphaerocyst type, claviform or fusoid-ventricose, hyaline or of a pale yellow color in KOH and in Melzer’s solution, and sized 20 - 36 × 5.6 - 12.8 μm. Some tetrasterigmate caulobasidia, sized 20 - 26.5 × 7.2 - 12 μm and hyaline to pale yellow in KOH and Melzer’s solution, are also present.
Habitat
Solitary to subrgregarious in Quercus forests, particularly beneath Quercus fusiformis, Q. polymorpha and Q. canbyi, at altitudes of 300 to 1 600 m (Figure 1).
Geographic distribution
The species is distributed from North Carolina and Florida to southern Texas. In Mexico, it is known in Nuevo León and Tamaulipas, and possibly in other northeastern states as well (Figure 2).
Edibility
Boletus luridellus is edible, according to Metzler and Metzler (1992) and Bessette et al. (2016). There is no history of consumption of this or other Boletaceae species of the northeastern region of Mexico.
Examined material
Nuevo León: Linares municipality, Universidad Autónoma de Nuevo León, Facultad de Ciencias Forestales. 15-X-2011, 10-X-2012; 12-X-2014; 15-10-2016; 9-X-2017. Garza 3900, 4025, 4189, 4230, 4600(CFNL). Nuevo León: Santiago municipality, El Ranchito, 14-IX-1979, García 59 (UNL, ITCV) El Cercado, 10-X-1984, A. Moreno s/n (ITCV), Puerto Genovevo, 14-X-1979, García 63 and Marmolejo 30 (UNL, ITCV). Tamaulipas: Victoria municipality, Cañón de La Libertad, 14-IX-1991, García 7405 (ITCV); the same municipality, km 155 of the Tula - Cd. Victoria road, Altas Cumbres ejido, 15-IX-1991, García 7433; Las Mulas ejido, 13-IX-2008, García 17,468 (ITCV). Casas municipality, km 80 of the Cd. Victoria-Soto La Marina road, 1-VII-1993, García 8530,1-X-1993; García 8751, 6-X-1993; García 8796, 27-VI-1994; García 8949 and 8951, 24-V-1997; García 10,580 and 10,586 (all at the Instituto Tecnológico de Ciudad Victoria (Technological Institute of Ciudad Victoria), ITCV. Victoria municipality, 30-VIII-1998, García 11050 and 11053 (ITCV); road from Huizachal to Puerto Arrazolo, 29-VIII-1998, García 11002 (ITCV). Victoria municipality, Cañón del Novillo, 21-X-1992, García 8280(ITCV); Jaumave municipality, near Rancho La Reja, 8-IX-1994, García and Martínez Ávalos 9028-D.
Multiple mean test for differences among strains
The results of the ANOVA show that there are significant differences in the effect of the strain*medium interaction with a model F value F= 482.78, and significance values below (P<0.05.) with F=81.05 for the effect of the strain*medium interaction. Tukey’s test evidenced that the treatment of strain 4 with the Melin-Norkrans medium was the best, as it exhibited the greatest growth of the Boletus luridellus colony (Figure 3). Table 1 shows the results of the analysis of the test of between-subjects effects.
Scale 2 cm.
Figure 3 Pure in vitro culture of Boletus luridellus (Murr.) Murrill in Melin-Norkrans medium at 15 days.
Table 1 Test of between-subjects effects.
| Source | Type III Sum of squares | Degrees of freedom | Average of squares | F value | Sig. |
|---|---|---|---|---|---|
| Corrected model | 44.807a | 7 | 6.401 | 482.587 | 0.000 |
| Interception | 935.028 | 1 | 935.028 | 70 494.267 | 0.000 |
| Medium | 21.945 | 1 | 21.945 | 1 654.502 | 0.000 |
| Strains | 19.636 | 3 | 6.545 | 493.480 | 0.000 |
| Mean * Strains | 3.225 | 3 | 1.075 | 81.057 | 0.000 |
| Error | 0.955 | 72 | 0.013 | ||
| Total | 980.790 | 80 | |||
| Corrected total | 45.762 | 79 |
aR2 = 0.979; adjusted R2 = 0.977.
The results for growth in a pure in vitro culture prove that the four strains grow better in the Melin medium than in Malt Extract. The monthly average growth of strains 4, 1, 3 and 2 in the Melin-Norkrans medium was 3.9 cm, while the average monthly growth observed in Malt Extract was 2.8 cm. Strain 4 had a higher growth in both culture media, and strains 2 and 3 registered the lowest values in the Melin-Norkrans medium and in Malt Extract, respectively. The growth rate differed significantly between the four strains and in the two culture media utilized (Figure 4).
Description of the strains
Mycelium growth in vitro was observed to be somewhat shiny, of a brown color and releasing a dark brown pigment around the colony, while the agar adopts a pale ochre hue in the Melin-Norkrans medium (Figure 3). The colony has a semicircular growth, mainly on the surface on top of the agar, although it also exhibits this growth into the medium; however, the mycelium does not penetrate all the way to the base of the dish. The superficial mycelium in the colony is compact and tight at the center of the colony, and lax or loose in its most aerial part.
The colony has a light ochre color at its margins, while its center is darker, with dark brown droplets; the agar takes on a light ochre hue at the edges of the colony. The hyphae have a diameter of 2 - 3.5 μm; they are hyaline in a 10 % KOH solution, and yellow in Melzer’s reagent; they are smooth and branched, septated, with sparse fibulae; the walls of the hyphae are thin, barely 1μm thick.
Production of fruits and ectomycorrhizae
Sporomes were produced in 75 % of the containers. The mycorrhizae are shiny and brown, monopodial and branched; they exhibit a well developed fungal mantle of a brown color and a thickness of 120 μm; the mantle has compact hyphae with no emerging cells and is dextrinoid in Melzer’s reagent. Development of the Hartig network was observed.
Colonization
The average percentage of mycorrhization in the root system was 75-100 %. Formation of mycorrhizae in 25 % of the tips of the root and the presence of a scarcely developed fungal mantle were observed (figures 5 and 6).

Scale 1 mm
Figure 5 Branched mycorrhizae and mycelium of Boletus luridellus (Murr.) Murrill and Quercus fusiformis Small.

Figure 6 Production of Boletus luridellus(Murr.) Murrill sporomes in Quercus fusiformis Small seedlings inoculated in a nursery at six months of the inoculation.
Boletus luridellus grows by associating with Quercus virginiana, Q. fusiformis and Quercus polymorpha in Nuevo León and Tamaulipas. it is likely that it may be associated to other species of oaks of the northeast region of the country. In the United States of America, it occurs in North Carolina, southern Florida and western Texas (Bessette et al., 2016).
The oak species mentioned above have been planted in many urban and suburban areas in Nuevo León and Tamaulipas and they also exist in commercial nurseries in the citrus producing area of the state of Nuevo León.
This macromycete is mycorrhizal, and its presence in Texas has been cited by Metzler and Metzler (1992) and by Bessette et al. (2016), according to whom it is edible and has an exquisite flavor. Boletus luridellus does not involve any toxicity issues, unlike the Scleroderma texense Berk. S. Pers. strain, which grows in gardens, squares, and recreational centers in urban and suburban areas of Nuevo León, where various species of oaks have been planted.
The fungal material collected in Nuevo León has a slightly acidic taste in young specimens, and a somewhat sweet taste in mature specimens. It is edible, and only young individuals that are free of insect larvae are recommended for consumption. Abundant sporomes weighing 1.5 to 2 kg per tree are produced in inoculated trees growing in gardens. The inoculation procedures would have positive repercussions in order to reforest with preinoculated seedlings that may later produce edible sporomes of the selected species.
Cistus ladanifer L. (gum rockrose or labdanum) seedlings are inoculated in vitro in Spain; these belong to the family Cystaceae and are obtained from the culture of tissues with Boletus edulis, of which experimental plantations have already been made quite successfully in terms of the production of sporomes (Agueda et al., 2006; Mediavilla et al., 2016).
Boletus luridellus was registered for the first time in Mexico by García (1999), and this study documents the first record for Nuevo León.
There are no previous differences for the species in regard to their culture. The obtained strains produce a colony of dark brown mycelia and dye the agar dark brown beneath the colony in both media; these results are similar to those obtained for Boletus luridus Schaeff. (Iotti et al., 2005). This dyeing characteristic also occurs in other macromycete cultures obtained by the first author, such as Suillus lakei (Murr.) A.H. Sm. & Thiers and Suillus granulatus (L.) Russell or Exsudoporus frostii (J.L. Russell) Vizzini, Simonini & Gelardi, besides other species like Pisolithus arhizus (Scop) Rasuchert. Díaz et al. (2009) studied certain species of Boletaceae in vitro and succeeded in producing small primordia, although they did not conduct experiments at a nursery to produce sporomes. Pantidou (1961, 1962) obtained them thus in vitro from the saprobe fungus Phlebopus sulphureus (Quél.) Singer and from P. lignicola (Kallenb.) M. M. Moser ex Groves. Chung et al. (2010) inoculated Pinus radiata D. Don seedlings with Boletus edulis Bull. and B. pinicola (Vittad.). In Chile, Vassilkov, C. R. determined that the mycorrhizae persisted in the field after 24 months, and that these seedlings had better growth responses than those that were not inoculated.
Conclusions
Several strains of Boletus luridellus were obtained in a pure culture and were reproduced in order to inoculate Quercus fusiformis seedlings. The inoculated plants produced sporomes in containers under nursery conditions. This is the first study carried out with this approach for Boletus luridellus, and it documents its first register in Nuevo León, Mexico.
Referencias
Agreda, T., L. M. Fernández y F. Martínez. 2010. Los Hongos y El Bosque: principales especies, su ecología y aprovechamiento en Soria. Editado por Cesefor. Departamento de Investigación y experiencias forestales de Valonsadero. Castilla y León, Valladolid. España. 377 p. [ Links ]
Águeda, B., J. Parlade, A. de Miguel and F. Martínez. 2006. Characterization and identification of field ectomycorrhizae of Boletus edulis and Cistus ladanifer. Mycologia 98 (1): 23-30. [ Links ]
Álvarez, J., R. Garibay and M. E. Smith. 2017. Caryophyllales are the main hosts of a unique set of ectomycorrhizal fungi in a Neotropical dry forest. Mycorrhiza 28(2): 103-115. https://doi.org/10.1007/s00572-017-0807-7. [ Links ]
Arora, D. 1986. Mushrooms demystified: A comprehensive guide to the fleshy fungi. 2nd edition. Ten Speed Press. Berkeley, CA, USA. 959 p. [ Links ]
Arora, D. 2008. California porcini: three new taxa, observations on their harvest, and the tragedy of no commons. Economic Botany 62: 356-375. [ Links ]
Bessette, A. E., W.C. Roody and A.R. Bessette. 2000. North American Boletes. A Color Guide to the Fleshy Pored Mushrooms. Syracuse University Press. New York, NY, USA. 400 p. [ Links ]
Bassette, A. E., W. C. Roody and A. R. Bassette. 2016. Boletes of Eastern North America. 1st edition. Syracuse University Press. Syracuse, NY USA. 471 p. [ Links ]
Both, E. E. 1993. The Boletes of North America: A compendium. Museum of Science. Buffalo, NY, USA. 436 p. [ Links ]
Brundrett, M., N. J. Bougher, B. Dell, T. Grove and N. Malajczuk. 1996. Working with mycorrhizas in forestry and agriculture. Australian Centre for International Agricultural Research. Monograph 32. Canberra, Australia. 374 p. [ Links ]
Chung, P., J. C. Pinilla, K. Casanova y H. Soto. 2010. Incorporación de Boletus edulis y Boletus pinicola en plantaciones de Pinus radiata en Chile. In: Martínez C., D., N. Curvetto, M. Sobal, P. Morales y V.M. Mora (eds.). Hacia un desarrollo sostenible del sistema de producción-consumo de los hongos comestibles y medicinales en Latinoamérica. Avances y perspectivas en el siglo XXI. Red Latinoamericana de Hongos Comestibles y Medicinales. Colpos-UN-Conacyt-AMC-UAEM-UPAEP-IMINAP. Puebla, Pue., México. 648 p. [ Links ]
Corner, E. J. H. 1972. Boletus in Malaysia. Singapore Botanic Gardens. Government Printing Office. Cluny Road, Singapore. 263 p. [ Links ]
Dentinger, B. T. and L. M. Suz. 2014. What’s for dinner? Undescribed species of porcini in a commercial packet. Peer J 2:e570. https://doi.org/10.7717/peerj.570. [ Links ]
Díaz, G., Flores, R., Honrubia, M. 2009. Descripción de cultivos miceliares de Boletales neotropicales y europeos (Boletus grupo edulis, Boletellus y Suillus) y formación de primordios de B. edulis en cultivo puro. Revista Mexicana de Micología, 30-17. [ Links ]
Kuo, M. 2013. The Boletes Retrieved from the The Boletes Retrieved from the https://www.mushroomexpert.com/ (29 de octubre de 2018). [ Links ]
García, J. 1999. Estudio sobre la taxonomía, ecología y distribución de los hongos de la Familia Boletaceae (Agaricales, Basidiomycetes) de México. Tesis de Maestría, Facultad de Ciencias Forestales, Universidad Autónoma de Nuevo León. Linares, N.L., México. 450 p. [ Links ]
García, J. y F. Garza. 2000. Conocimiento de los hongos de la familia Boletaceae en México. Ciencia UANL 4(3): 336-343. [ Links ]
Garza, F., M. Quiñónez, V. Chacón, L. Garza, Q. Carrillo and E. Cázares. 2009. Sustainable management of edible forest mushrooms in Chihuahua, México. Actes du Colloque International des Champignons forestiers Comestibles a Potentiel Commercial. Université Laval, Quebec, Canada. pp. 105-118. [ Links ]
Garza F., E. Cázares, A. Carrillo, L. Garza y M. Quiñónez. 2011. La economía micológica en bosques templados y plantaciones: un enfoque educativo-productivo para el desarrollo socioeconómico rural, el manejo sostenible y la conservación de los hongos silvestres comestibles de México. In: Garza O., F. y A. Carrillo P. (eds.). Economía en el manejo sustentable de los recursos naturales. Universidad Autónoma de Nuevo León. Linares, NL., México. 140p. [ Links ]
Garza, F., A. Carrillo, L. Garza, M. Quiñónez, J. García y G. Guevara. 2014. Técnicas para el manejo de hongos ectomicorrícicos: del bosque al laboratorio y viceversa. In: Garza O. F., J. A. Guevara G., H. Villalón M. y A. Carrillo P. (eds.).Técnicas en el manejo sustentable de los recursos naturales. Universidad Autónoma de Nuevo León. Linares, NL., México. pp. 72-119. [ Links ]
Iotti, M., E. Barbieri, V. Stocchi and A. Zambonelli. 2005. Morphological and molecular characterisation of mycelia of ectomycorrhizal fungi in pure culture. Fungal Diversity 19: 51- 68. [ Links ]
Maerz, A. and M. R. Paul. 1930. A dictionary of color. McGraw -Hill. New York, NY USA. 207 p. [ Links ]
Mediavilla, O., J. Olaizola, L. Santos-del-Blanco, J. A. Oria-de-Rueda y P. Martín-Pinto. 2016. Mycorrhiza tion between Cistus ladanifer L. and Boletus edulis Bull is enhanced by the mycorrhiza helper bacteria Pseudomonas fluorescens Migula. Mycorrhiza 26(2): 161-8. [ Links ]
Metzler, S. and V. Metzler. 1992. Texas Mushrooms. University of Texas Press. Austin, TX, USA. 360 p. [ Links ]
Muñoz, J. A. 2005. Fungi Europaei, Boletus s.l. (Excl. Xerocomus) Strobilomycetaceae, Gyroporaceae, Gyrodontacae, Suillaceae, Boletaceae. Edizione Canduso. Roma, Italy. 938 p. [ Links ]
Pantidou, M. E. 1961. Carpophores of Phlebopus sulphureus in culture. Canadian Journal of Botany 39: 1163-1167. [ Links ]
Pantidou, M. E. 1962. Cultural studies of Boletaceae: carpophores of Phlebopus lignicolain culture. Canadian Journal of Botany 40: 1313-1319. [ Links ]
Singer, R. 1986. The Agaricales in Modern Taxonomy. 4th ed. Koeltz Scientific Books. Koenigstein, Germany. 805 p. [ Links ]
Sitta, N. and P. Davoli. 2012. Edible ectomycorrhizal mushrooms: international markets and regulations. Edible ectomycorrhizal mushrooms. Springer. Berlin, Germany. pp. 355-380. [ Links ]
Smith, A. H. and H. D. Thiers. 1971. The Boletes of Michigan. The University of Michigan Press. Ann Arbor, MI, USA. 428 p. [ Links ]
Tedersoo, L., T. W. May and M. E. Smith. 2010. Ectomycorrhizal lifestyle in fungi: global diversity, distribution, and evolution of phylogenetic lineages. Mycorrhiza 20:217-263. [ Links ]
Villarreal, L. and A. Gómez. 1995. Inventory and monitoring wild edible mushrooms in Mexico: challenge and opportunity for sustainable development. In: Palm, M. E. and I. H. Chapela (eds.). Sustainable Mycology. Berkeley, CA, USA. pp. 99-109. [ Links ]
Received: March 15, 2018; Accepted: October 24, 2018











 texto em
texto em 





